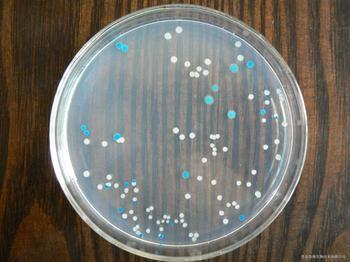
产品封面图

万千商家帮你免费找货
0 人在求购买到急需产品
- 详细信息
- 文献和实验
- 技术资料
- 保存条件:
低温避光保存
- 保质期:
详见说明书
- 英文名:
3%NaCl amino aciddecarboxylasecontrol
- 库存:
28
- 供应商:
上海莼试
- 规格:
详见说明书
| 产品名称 | 英文名称 | 保存 | 发货地 |
| 3%NaCl 氨基酸脱羧酶对照现货供应 | 3%NaCl amino aciddecarboxylasecontrol | 低温避光保存 | 上海 |
英文名称:3%NaCl amino aciddecarboxylasecontrol
规格:1ml×10 支/盒
作用:
型号:CS-PYJ0767
使用范围:仅供科研使用
库存:提供现货(因销量问题库存会有变动,具体请与销售人员确认)
保存:低温避光保存
3%NaCl 氨基酸脱羧酶对照现货供应的清洗方法:
1、新购的玻璃器皿
除去包装沾染的污垢后,先用热肥皂水刷洗,流水冲净,再浸泡于1~2%的工业盐酸中数小时,使游离的碱性物质除去,再以流水冲净。对容量较大的器皿,如大烧瓶、量筒等,洗净后注入浓盐酸少许,转动容器使其内部表面均沾有盐酸,数分钟后倾去盐酸,再以流水冲净,倒置于洗涤架上将水空干,即可使用。
2、用过的玻璃器皿
凡确无病原菌或未被带菌物污染的器皿,使用后可随时冲洗,吸取过化学试剂的吸管,可先浸泡于清水中,待到一定数量后再集中进行清洗。有可能被病原菌污染的器皿,必须经过适当消毒后,将污垢除去,用皂液洗刷,再用流水冲洗干净。若用皂液未能洗净的器皿,可用洗液浸泡适当时间后再用清水洗净。洗液的主要成份是重铬酸钾和浓流酸,其作用是将有机物氧化成可溶性物质,以便冲洗。洗液有很强的腐蚀作用,使用时应特别小心,避免溅到衣服、身体和其他物品上。
3%NaCl 氨基酸脱羧酶对照现货供应【注意事项】:由于液体培养基不易长期保管,现在均改制成粉末。
贮存方法:培养基由于配制的原料不同,使用要求不同,而贮存保管方面也稍有不同。一般培养基在受热、吸潮后,易被细菌污染或分解变质,因此一般培养基必须防潮、避光、阴凉处保存。对一些需严格灭菌的培养基(如组织培养基),较长时间的贮存,必须放在2~6℃的冰箱内。由于液体培养基不易长期保管,现在均改制成粉末。营养培养基是在基础培养基中添加一些其它营养物质,如葡萄糖、血液、血清、酵母浸膏等,可供营养要求较高的细菌生长,常用的有血液琼脂斜面及平板。
FCARProteinRat重组大鼠 CD89 / FCAR 蛋白 (His 标签)
IL1R1ProteinRat重组大鼠 IL1R1 / CD121a 蛋白 (His 标签)
NXPH1ProteinRat重组大鼠 Neurexophilin-1 / NXPH1 蛋白 (His 标签)
FASProteinRat重组大鼠 FAS / CD95 / APO-1 / TNFRSF6 蛋白 (His 标签)
CST3ProteinRat重组大鼠 Cystatin C / CST3 蛋白 (His 标签)
MMP9ProteinRat重组大鼠 MMP-9 / CLG4B 蛋白 (His 标签)
FCGR2BProteinRat重组大鼠 CD32b / FCGR2B 蛋白 (His 标签)
CRPProteinRat重组大鼠 CRP / C-Reactive 蛋白 (His 标签)
FCGR3AProteinRat重组大鼠 CD16a / FCGR3A 蛋白 (His 标签)
ICAM1ProteinRat重组大鼠 ICAM-1 / CD54 蛋白 (His 标签)
CD86ProteinRat重组大鼠 CD86 / B7-2 蛋白 (His 标签)
FCGR1ProteinRat重组大鼠 CD64 / FCGR1A 蛋白 (His 标签)
CNTFRProteinRat重组大鼠 CNTFR / CNTFR-alpha 蛋白 (His 标签)
GHRProteinRat重组大鼠 Growth Hormone Receptor / GHR / GHBP 蛋白 (His 标签)
IL6STProteinRat重组大鼠 gp130 / IL6ST / CD130 蛋白 (His & Fc 标签)
GFRA1ProteinRat重组大鼠 GFRA1 / GFR alpha-1 蛋白 (His 标签)
ERBB2ProteinRat重组大鼠 HER2 / ErbB2 蛋白 (His 标签)
ERBB2ProteinRat重组大鼠 HER2 / ErbB2 蛋白 (Fc 标签)(Fc 标签)
ERBB2ProteinRat重组大鼠 HER2 / ErbB2 蛋白
IL1BProteinRat重组大鼠 IL-1 beta / IL1B 蛋白 (pro form, His 标签)
SOSTProteinRat重组大鼠 Sclerostin / SOST 蛋白 (His 标签)
RBP4ProteinRat重组大鼠 RBP4 蛋白 (His 标签)
3%NaCl 氨基酸脱羧酶对照现货供应大鼠γ谷氨酸-半胱氨酸合成酶(γ-GCS)ELISA Kit Rat γ glutamylcysteine synthetase,γ-GCS ELISA kit
大鼠γ干扰素受体(IFN-γR)ELISA Kit Rat Interferon γ Receptor,IFN-γR ELISA Kit
大鼠γ分泌酶ELISA Kit Rat γ-secretase ELISA kit
大鼠γ-氨基丁酸受体亚基α1(GABRA1)ELISA Kit Rat Gamma-aminobutyric acid receptor subunit alpha-1,GABRA1 ELISA kit
大鼠β-转导重复相容蛋白(β-TrCP)ELISA Kit Rat β-transducin repeat-containing proteins,β-TrCP ELISA Kit
大鼠β细胞素(BTC)ELISA Kit Rat beta cellulin,BTC ELISA Kit
大鼠β位淀粉样前体蛋白裂解酶1(BACE1)ELISA Kit Rat β-site APP-Cleaving Enzyme 1,BACE1 ELISA Kit
大鼠β干扰素(IFN-β/IFNB)ELISA Kit Rat Interferon β,IFN-β/IFNB ELISA Kit
大鼠β防御素2(DEFB2)ELISA Kit Rat beta-defensin 2,DEFB2 ELISA kit
大鼠β-防御素(β-Defensins)ELISA Kit Rat β-Defensins ELISA Kit
大鼠β半乳糖苷酶(βGAL)ELISA Kit Rat β-galactosidase,βGAL ELISA Kit
大鼠β2整合素(ITG β2/CD11+CD18)ELISA Kit Rat integrin β2,ITG β2/CD11+CD18 Elisa Kit
大鼠β1整合素(ITG β1)ELISA Kit Rat integrin β1,ITG β1 ELISA Kit
大鼠α烯醇化酶(α-enolase)ELISA Kit Rat α-enolase ELISA Kit
大鼠α平滑肌肌动蛋白(α-SMA)ELISA Kit Rat α-Smooth muscle actin,α-SMA ELISA Kit
大鼠α肌动蛋白(α Actin)ELISA Kit Rat Alpha-Actin,α Actin ELISA Kit
大鼠α谷胱甘肽S转移酶(α-GST)ELISA Kit Rat α-glutathione S-transferases,α-GST ELISA Kit
大鼠α-辅肌动蛋白1(ACTN-1)ELISA Kit Rat α-Actinin 1, ACTN-1 ELISA Kit
大鼠α2巨球蛋白(α2-MG)ELISA Kit Rat α2 macroglobulin,α2 MG ELISA Kit
大鼠α2-HS糖蛋白(AHSG)ELISA Kit Rat Alpha 2 Heremans Schmid Glycoprotein,AHSG ELISA Kit
大鼠α1抗胰蛋白酶前体(pre-α1-AT)ELISA Kit Rat α1-Antitrypsin Precursor,pre-α1-AT ELISA Kit
大鼠VGF神经生长因子诱导蛋白(VGF)ELISA Kit Rat VGF Nerve Growth Factor Inducible,VGF ELISA Kit
风险提示:丁香通仅作为第三方平台,为商家信息发布提供平台空间。用户咨询产品时请注意保护个人信息及财产安全,合理判断,谨慎选购商品,商家和用户对交易行为负责。对于医疗器械类产品,请先查证核实企业经营资质和医疗器械产品注册证情况。
文献和实验氨基酸脱羧酶试验的概述是检验主管技师考试辅导的部分内容,以下是医学教育网对这块内容的整理,希望对考生有所帮助: (1)培养基:氨基酸脱羧酶培养基和氨基酸对照培养基。 (2)方法:将被检菌分别接种于赖氨酸(或鸟氨酸或精氨酸)培养基和氨基酸对照培养基中,并加入无菌液体石蜡或矿物油,于35℃培养l~4d,每日观察结果。 (3)结果:对照管应呈黄色,测定管呈紫色(指示剂为溴甲酚紫)为阳性,若测定管呈黄色为阴性。若对照管呈现紫色则试验无意义,不能作出判断。
,上面滴加一层液体石蜡,115℃高压灭菌10min. 试验方法 从琼脂斜面上挑取培养物接种,于36±1℃培养18~24h,观察结果。氨基酸脱羧酶阳性者由于产碱,培养基应呈紫色。阴性者无碱性产物,但因葡萄糖产酸而使培养基变为黄色。对照管应为黄色。
Yeast exoglycoproteins produced under NaCl-stress conditions as efficient cryoprotective agents
into growth medium containing NaCl (8% w/v) were found to be the most effective cryoadditives. It was possible to use these glycoproteins alone (without DMSO as penetrating agent) for the cryoprotection of the studied yeasts.
技术资料暂无技术资料 索取技术资料